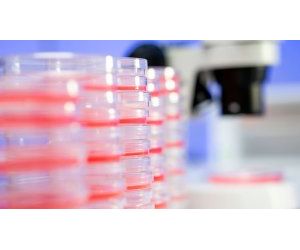

- Home
- Companies
- Clinisys, Inc.
- Services
- Clinisys - Microbiology Laboratory ...

Clinisys - Microbiology Laboratory Solution
A microbiology solution for the modern laboratory. Offering all the advantages of a modern laboratory information management system (LIMS), Clinisys Microbiology Laboratory encompasses Bacteriology, Virology, Infection Control, Environmental and Epidemiology services. Our solution supports paperless processes allowing you to build, customise, and control your unique laboratory workflow.
Employ workflows that deliver traceability for the whole sample journey, guiding users through sample processes and reducing interpretative errors by using both rules based and standard test batteries. Provide standardised culture identification and confirmation processes.
Identify organisms by their proper taxonomy and group into user-definable classifications for ease of searching and action by rules base. Improve workflows and turnaround times through innovative features around automatic resulting and reporting, alongside flexible handling of duplicate testing.
Incorporates microbiology-specific request entry, result entry, clinical authorisation, and reporting elements. The system is intuitive, easy to use, flexible, and fully customisable. Key features include an integral rules base, comprehensive audit trail, and user-defined screens throughout.
Enables both manual and automatic reportability options for sensitivities and isolates together with the ability to record and interpret zone size and MIC values. All areas are further augmented by the extensive microbiology-specific rules base.

Facilitates tracking and reporting of hospital infections and outbreaks, effortlessly. Actively used for infection control traceability within the Infection Control department ensuring immediate notification of notifiable pathogens as they are entered.
Seamlessly integrates with key microbiology and virology platforms. With proven connectivity, our systems allow integration ID and susceptibility platforms, allowing automated workflows to streamline and accelerate result reporting.

